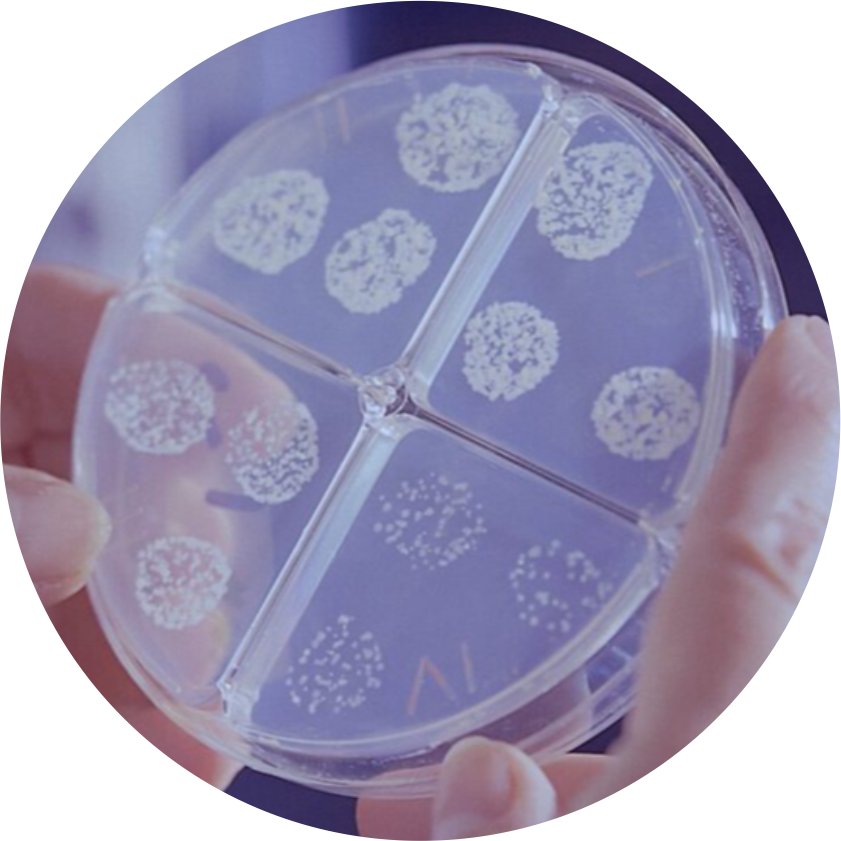

| Комплексное оснащение химической и микробиологической лабораторий | |
| | Компания "Химмед" предлагает Вашему вниманию:
| |
| | | Готовые питательные среды | |  | | Добавки и компоненты для приготовления питательных сред | |  | | Наборы для идентификации микроорганизмов;
Готовые растворы красителей;
Дифференциальные бумажные диски и полоски;
Наборы для окрашивания микроорганизмов (окраска по Грамму);
Готовые растворы тест-реактивов. | |  | | Флаконы и картриджи с дисками для определения чувствительности к антибиотикам
| |  | |
| | Транспортные системы (свабы) | |  | | Контрольные штаммы микроорганизмов (диски, петли Culti-Loops) | |  | | Химические реактивы и красители | | |
|  | | Оперативные прямые поставки со склада производителя во все регионы России. | |  | | Доставка товара: 60-90 дней. | |  | | Доставка товара осуществляется с соблюдением температурного режима. | | |
| | | Чтобы отписаться от получения рассылок нажмите здесь | |
| |